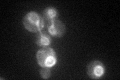
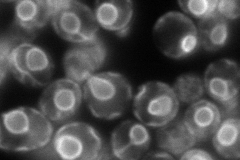
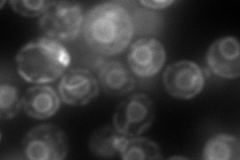
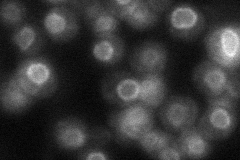
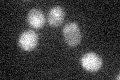

View description
C-14 sterol reductase, acts in ergosterol biosynthesis; mutants accumulate the abnormal sterol ignosterol (ergosta-8,14 dienol), and are viable under anaerobic growth conditions but inviable on rich medium under aerobic conditions
Localization:
Intensity:
Fold change:
Significance:
-
C’ GFP library in SD
ER57.32 -
N' NOP1pr-GFP in SD
ER151.836 -
N' TEF2pr-mCherry in SD
ER219.261 -
N' NATIVEpr-GFP in SD
nuclear periphery42.7517 -
N' TEF2pr-VC and Cyto-VN in SD

ER48.4857 -
C’ GFP library in SD+DTT

ER39.810.69No -
C’ GFP library in SD+H2O2

ER24.360.42Yes -
C’ GFP library in Starvation Media
ER18.890.32Yes -
C’ GFP library on the background of Pup2-DaMP

ER -
C’ GFP library on the background of CCT mutant

ER22.26160.388304Yes
